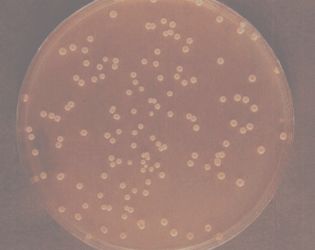

“痘痘长在哪里你最不担心呢?”

“当然是长在别人脸上啦!”
生活中“为痘所困”的人太多了,不知道你是不是其中一员呢?
痘痘生的油腻,死的难看,长在脸上要多烦人就多烦人,有没有一种“战痘”神器,能将痘痘一举消灭呢?痘痘贴给了大家希望。

让你花容失色的罪魁祸首是谁?
俗话说,知己知彼百战百胜,今天我们就来好好扒一扒痘痘的老底。我们口中的痘痘,一般指的是痤疮,它的俗名还有“青春痘”“粉刺”“暗疮”“酒刺”等几种。痤疮实质上是一种毛囊皮脂腺的慢性炎症,主要表现是在皮肤上出现白头或黑头粉刺、丘疹、脓疱、结节和囊肿。

常见痤疮问题,图片来源 www.gylyx.com
那痤疮是怎么形成的呢?原因主要有这么几个:体内雄性激素水平偏高、毛囊角质化异常、细菌感染以及细胞因子等介导的炎症[1]。

皮肤毛囊结构图,图片来源 dev.soyoung
遗传因素或者内分泌紊乱使体内雄性激素水平偏高,皮脂腺肥大,导致皮脂分泌过多。
毛囊上皮角质化异常时,角质增厚且不易脱落,毛囊口变细,毛囊皮脂腺导管阻闭,皮脂流出受阻,堵塞在毛囊口,就形成了粉刺。
被堵塞的毛囊形成缺氧环境且充满皮脂和细胞碎片,是痤疮丙酸杆菌理想的繁殖基地。
痤疮丙酸杆菌是一种厌氧型革兰氏阳性菌,是类白喉菌的一种,在有氧条件下不活动且无致病性。
痤疮丙酸杆菌菌落形态,图片来源《痤疮诊治彩色图谱》
但在毛囊口闭塞形成的厌氧环境中,痤疮丙酸杆菌则会大量繁殖,产生蛋白酶、脂酶等多种水解酶。
这些酶分解皮脂中的甘油三酯,并产生大量游离的脂肪酸,引起促炎症因子和中性粒细胞聚集,介导炎症的发生。
同时,大量繁殖的痤疮丙酸杆菌还会破坏毛囊皮脂腺结构,在皮肤上形成红疙瘩。
另一方面,大量脂肪酸的存在反过来刺激毛囊皮脂腺导管,使其增生,加剧了皮脂腺分泌异常[2]。这也是爱出油的人更容易发生痤疮的原因之一。

说到这儿,肯定有人要问“为什么某某也容易出油,但不怎么长痘呢”?
那是因为有的人天赋异禀,皮肤虽然油脂分泌多,但毛囊皮脂腺漏斗部较宽,不会发生堵塞,当然也就不怎么长痘了。
通常来说,遗传、某些药物、化妆品、外界环境以及精神因素都可能是痤疮的诱发因素。此外,长期佩戴口罩也可能导致长痘[3]。
痘痘贴的真身是什么?
说了这么多痘痘的成因,那痘痘贴治得了痘痘吗?别急,我们先来看看痘痘贴到底是什么。痘痘贴又被称为“水胶体贴片”,它是在水胶体敷料的基础上演变而来的,只是外形和成分都发生了改变。

网上各式的痘痘贴,图片来源小红书
医用水胶体敷料是将合成橡胶、聚合水凝胶和黏性物质混合加工而形成的一种生物活性敷料,其实是用于各种开放性伤口的。
这种材料既有水胶体的吸水性,还有橡胶材料的黏合性。贴上后,橡胶材料能使敷料粘贴在伤口上,水胶体颗粒会吸水,进而为创伤面愈合提供一个较为理想的环境[4]。
痘痘贴真的有效吗?
既然医用水胶体敷料有助于伤口愈合,那对痘痘是不是也有作用呢?
要知道,水胶体敷料发挥作用的主要原理是,在伤口处形成密闭的微环境,保护这里的皮肤免受细菌的侵扰(要达到这个目的,清洁消毒工作必须做到位)。
类似的,痘痘贴也在痘痘附近形成了一个密闭的微环境,这样的微环境与外界隔绝,相对缺氧。
前面我们已经说过了,痤疮丙酸杆菌是厌氧菌,这样缺氧的微环境简直就是为它量身打造的(对于痘痘来说,不要太友好哦)。
此外,痘痘贴形成了小面积封包,使皮脂内容物在此处积累,而且会导致该处皮肤过度水合,反而加重痤疮。
可能有人会说,痘痘贴中含有抑菌成分,难道对痘痘无效?
还真是这样的,痘痘贴中的抑菌成分,只能抑制皮肤表面的细菌,而对皮脂腺中的罪魁祸首——痤疮丙酸杆菌并不能起到抑制作用。
综上,痘痘贴根本治不了痘痘。
当然,痘痘贴也不是一无是处。对有某些挤痘痘重度患者,还有有一定作用的。
这些人看到痘痘就想挤,挤完一个又一个,不弄到出血不罢休,结果就是增加细菌感染机会,留下坑坑洼洼的痘印。

贴上痘痘贴,能大大减少抚摸、按压和挤痘痘的几率,皮肤可以不受干扰慢慢自我修复,这让一些人感觉是痘痘贴起了作用
以上就是痘痘贴祛痘的真相了,你拔草了吗?
参考资料:[1] 孙莉, 李娟, 颜敏, 等. 痤疮的发病机制研究进展[J]. 山东医药, 2013, 53(032): 97-100.[2] 虞瑞尧. 痤疮诊疗图谱[M]. 北京科学技术出版社. 2010.[3] 翁淑贤. 长时间戴口罩 闷出痘痘怎么办?[J]. 中老年保健, 2020, No.322(08): 52-52.[4] 曾凡志. 医用水胶体敷料的制备及性能研究[D]. 湖北大学. 2014.
审核专家:徐宏俊,皮肤科主治医师。
蝌蚪五线谱原创文章/转载注明来源
责编/Sirens
版权声明:CosMeDna所有作品(图文、音视频)均由用户自行上传分享,仅供网友学习交流。若您的权利被侵害,请联系删除!
本文链接://www.cosmedna.com/article/418514219.html







